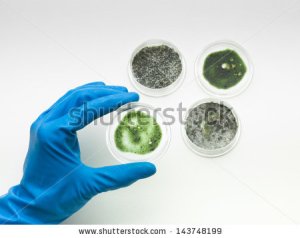
stock-photo-aerial-view-of-a-hand-in-a-blue-rubber-glove-holding-a-specimen-of-green-mold-in-a-petri-dish-with-143748199
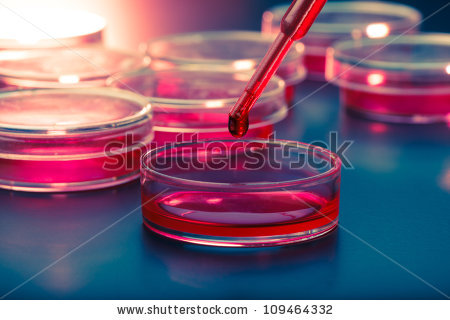

Mitt Romney – The Mormon’s and Bain capital
The seeds of Romney’s unique brand of conservatism, often regarded with intense suspicion by most non-Mormon conservatives, were sown in the secretive, acquisitive, patriarchal, authoritarian religious empire run by ‘quorums’ of men under an umbrella consortium called the General Authorities.
A creed unlike any other in the United States, from its inception Mormonism encouraged material prosperity and abundance as a measure of holy worth, and its strict system of tithing 10% of individual wealth has made the Church one of the world’s richest institutions.
A multibillion-dollar business empire that includes agribusiness, mining, insurance, electronic and print media, manufacturing, movie production, commercial real estate, defence contracting, retail stores and banking, the Mormon church has unprecedented economic and political power.
Despite a solemn stricture against any act or tolerance of gambling, Mormons have been heavily invested and exceptionally influential in the Nevada gaming industry since the great expansion of modern Las Vegas in the 1950s.
Valued for their unquestioning loyalty to authority as well as general sobriety–they are prohibited from imbibing in alcohol, tobacco or coffee–Mormons have long been recruited into top positions in government agencies and multi-national corporations.
They are prominent in such institutions as the CIA, FBI and the national nuclear weapons laboratories, giving the Church a sphere of influence unlike any other American religion in the top echelons of government.
“Romney, like his father before him who voluntarily tithed an unparalleled 19% of his personal fortune, is among the Church’s wealthiest members.
And like his father, grandfather and great-grandfathers before him, Mitt Romney was groomed for a prominent position in the Church, which he manifested first as a missionary, then as a bishop, and then as a stake president, becoming the highest-ranking Mormon leader in Boston — the equivalent of a cardinal of the Roman Catholic Church.
http://exmormon.org/d6/drupal/Are-Mormon-Romney-LDS-Chickens-Finally-Coming-Home-to-Roost
Horror Stories – Mitt Romney’s Shameful Record With Mormon Women
A candidate for leadership of the Republican Party in 2012 he knew it was important that he be portrayed as a moderate politician but troubling stories from career as a Mormon leader surfaced during the campaign exposing the true nature of his character when he served as a bishop and State president in the Church of Jesus Christ of the latter day Saints in Massachusetts. Full report:
http://www.huffingtonpost.com/geoffrey-dunn/mitt-romney-mormon-women_b_1956568.html
Bain Capital
The government recently sold UK plasma NHS supplier PRUK to US private equity firm Bain Capital.
The sale was processed against the advice of many knowledgable people and politicians and it is to be hoped there will be no repercussions for UK residents. History doesn’t lend itself to this view however.
Background information about Bain Capital makes interesting reading – There is a live connection between the UK and Bain through the Cayman and Channel Islands Tax havens.
Should the UK government sign off contracts with a company so blatantly avoiding UK taxes?
Mitt Romney Connection
For all Mitt Romney’s touting of his business record, when it comes to his own money the Republican nominee is remarkably shy about disclosing numbers and investments.
The world of offshore finance is murky, and rife with loopholes that allow the very wealthy to skirt tax laws, and much of Mitt Romney’s fortune (with $30 million in Bain Capital funds in the Cayman Islands alone?) which seems strange for a presidential candidate. Read More:
http://www.vanityfair.com/news/politics/2012/08/investigating-mitt-romney-offshore-accounts
Should I put my money in Caribbean Tax Havens Like Mitt Romney Does?
No. Moving your money to an obscure tax-haven sounds suspicious, but as far as anybody knows, Romney’s investments are above board.
If he was trying to hide his money, he’d be doing a pretty terrible job, considering all this information was discovered through public documents.
“I don’t care whether it’s the Cayman’s or Mars, if it’s organized in the Netherlands Antilles or the Jersey Islands,” he said. “That means nothing to me.
All I care about is whether it’s a good fund or a bad fund. It doesn’t affect his taxes.”
http://www.latimes.com/business/la-na-mittoffshore17dec17-story.html#page=1
After all, Malt even invested $1 million of Romney’s money in a fund run by the candidate’s own son, Tagg.
As ABC has reported, Romney’s blind trust probably wouldn’t be up to snuff for a federal elected official.
His campaign has acknowledged so much.
But since it was organized in Massachusetts, he got to meet a lower bar.
To the best of anyone’s knowledge, though, Romney isn’t calling the shots on his investment portfolio.
http://abcnews.go.com/Blotter/mitt-romneys-blind-trust-blind/story?id=15188063#.Txmk42NAYs1
That’s sounds really simple!
OCTOBER 2005: CLINTON BLOOD SCANDAL ERUPTS IN SCOTLAND
Daily Record, Scotland – Former US President Bill Clinton may be forced to appear in court over a medical scandal which claimed the lives of innocent Scots.
Many haemophiliacs were infected with hepatitis C after tainted blood from American prisoners was imported into the UK. Glasgow firm Thomson’s are representing the families of Scots sufferers who died after contracting the disease.
They allege inmates in an Arkansas jail were paid to donate blood despite the authorities knowing they had AIDS and hepatitis.
They are threatening to call the ex-president, who was state governor at the time, to the witness stand.
The infected blood was used to make clotting agents for haemophiliacs who require regular blood transfusions.
Frank Maguire, of Thomson’s, said “These allegations are extremely serious and I am now more sure than ever that there should be a full public inquiry into why so many Scots contracted hepatitis C from infected blood products.
October 2005: Documentary Examines Blood Scandal
A major new documentary that uncovers fresh evidence about how thousands of Scots contracted Aids and hepatitis through infected blood is to be given its world premiere at a prestigious US film festival.
The film, Factor 8: The Arkansas Prison Blood Scandal, made by the US film-maker Kelly Duda, will reveal new details about how inmates at a US jail were paid to donate blood despite the authorities knowing they had Aids and hepatitis.
It shows how the US state of Arkansas, under former president and then-governor Bill Clinton, allowed contaminated blood from Aids and hepatitis-infected prisoners to be exported around the world during the 1980s and 1990s to be used in the manufacture of clotting agents for haemophiliacs.
The documentary also reveals for the first time how senior figures in the prison system doctored prisoners’ medical records to make it look like they were not carrying the deadly diseases.
Even after it was known there was a problem, the film reveals, blood products were allowed to be supplied to Europe, including to the UK, where thousands of patients were infected with HIV and the potentially fatal liver virus, hepatitis.
Last night, the revelations caused outrage among haemophiliacs who contracted Aids and other diseases through the blood products.
They branded the findings unbelievable” and “shocking”, and demanded that the government launch a judicial inquiry into the so-called “tainted blood scandal”.
13 July 2013: Letter to Anna Soubry MP, Parliamentary Under Secretary of State for Health
I am writing to urge you to halt the acquirement of Plasma Resources UK by Bain Capital or, at the very least, to put in place strict restrictions on the way the company buys and uses blood products in order to safeguard the health of people in the UK.
There have already been many documented examples of serious damage to public health from an insufficiently regulated trade in blood products.
As I am sure you will be aware, the 2009 Archer Report into the widespread contamination of blood supplies given to those affected by haemophilia noted that profit-driven companies have an incentive to keep their costs down by being insufficiently discriminatory about donor selection.
In Canada, social unrest was triggered when an estimated 30,000 patients caught hepatitis C and 1,000 contracted HIV from transfusions and blood products, thanks to an unregulated, profit-driven market.
How can citizens trust a Government they see putting private profit before their own safety?
The purpose of Plasma Resources UK is to provide a safe, reliable source of plasma for UK residents, not to make a profit for a private American company with an abysmal track record, at the potential cost of the health and lives of UK citizens.
My constituents are concerned about its potential sale and I hope your Department will be willing to reconsider.
18 July 2013: Is there no limit to what this Government will privatise?’: UK plasma supplier sold to US private equity firm Bain Capital
The Government was tonight accused of gambling with the UK’s blood supply by selling the state-owned NHS plasma supplier to a US private equity firm.
The Department of Health overlooked several healthcare or pharmaceutical firms and at least one blood plasma specialist before choosing to sell an 80 per cent stake in Plasma Resources UK to Bain Capital, the company co-founded by Republican presidential candidate Mitt Romney, in a £230m deal.
The Government will retain a 20 per stake and a share of potential future profits.
PRUK has annual sales of around £110m and consists of two companies: it employs 200 people at Bio Products Laboratory (BPL) in Elstree, Hertfordshire, and more than 1,000 at DCI Biologicals Inc in the US.
DCI collects plasma from American donors and sends it to BPL where it is separated into blood proteins, clotting factors and albumin for supply to NHS hospitals in the treatment of immune deficiencies, neurological diseases, and haemophilia.
British jobs are being safeguarded in the deal and Bain, which has invested in dozens of private and state-owned health companies worldwide, is prepared to spend £50m in capital investment on the Elstree laboratories.
However, critics of the deal warned the Government that Bain Capital was the wrong company to own the NHS plasma supply line.
Lord Owen, the former Health Minister, wrote to David Cameron earlier this year asking the Prime Minister to intervene and halt the sale. He wrote:
“In 1975, against some resistance from those guarding the finances of the DHSS budget, I decided as Minister of Health to invest in self-sufficiency in the UK for blood and blood products, I now believe this country is on the point of making exactly the same mistake again.
The world plasma supply line has been in the past contaminated and I fear it will almost certainly continue to be contaminated.”
After hearing of the sale Lord Owen told The Independent: “It’s hard to conceive of a worse outcome for a sale of this particularly sensitive national health asset than a private equity company with none of the safeguards in terms of governance of a publicly quoted company and being answerable to shareholders. “Private equity has a useful function, as I saw in years past on the advisory board of Terra Firma, but Bain Capital should not have been chosen for this sale.
Is there no limit to what and how this coalition government will privatise?”
Blood from UK donors, typically collected in vans and centres by NHS Blood and Transplant, is not supplied to PRUK, a separate organisation.
Plasma donors at DCI centres in the US receive cash for each donation, typically around $25 for the first visit and $20 for any subsequent visit. People can donate up to twice a week.
Due to safety concerns following the emergence of ‘mad cow disease’, or vCJD, NHS hospitals only use plasma from around 20 per cent of blood collected from donors in the UK with the remainder used for diagnostic and research purposes.
As the UK was unable to secure a long-term ‘safe’ blood supply for the NHS following the vCJD outbreak, the Government spent £50m in 2002 on the US firm that provided all of BPL’s plasma.
The majority of NHS hospital plasma supplies come from PRUK, which sources all its plasma from low contamination risk groups in the United States across DCI’s network of 32 donor centres.
Lucy Reynolds from the London School of Hygiene and Tropical Medicine wrote an academic paper earlier this year strongly arguing against the sale of PRUK.
She said the Coalition deal undervalued the company adding:
“Plasma supplies have a long record of being operated on a not for profit basis, using voluntary donors where all the necessary checks take place.
The difference with a commercial firm is that they will want to have as many donors as possible and be looking to secure large profits first and foremost.
This amounts to the government abandoning UK blood products users to the tender mercies of the cheapest supplier.”
The PRUK deal is the latest move from Bain Capital into the expanding privatised UK health market.
The Independent reported last month that the Hospital Corporation of America (HCA), co-owned by the assets management firm, already caters for around half of all private patients in London and runs three joint NHS ventures, renting building space from public hospitals for exclusively private treatment.
HCA is also a large buyer of plasma-derived products.
Devin O’Reilly, managing director of Bain Capital in London, said: “We have completed over 50 healthcare investments in companies such as HCA and we will ensure that all of this experience and expertise is applied to building PRUK into a true global leader.”
Health Minister Dan Poulter said: “This deal will ensure that patients will have access to high quality plasma products for years to come and it is good news that Bain are investing in medicine and the life science industry in the UK.”

“‘Politics and Parasites’”
http://syzygysue.com/2013/08/03/politics-and-parasites/
LikeLike
Thank you for the link. I have added it to this article: https://caltonjock.com/2015/06/07/tax-havens-and-the-torys-will-they-honour-their-manifesto-give-up-their-secret-nest-eggs-to-the-taxman-pigs-will-fly-first/
We Scots need to “waken up and smell the coffee”. The last referendum provided evidence-a-plenty of the abuses the ” Bitter Together” campaign imposed on the Scottish Electorate. The government’s well organised (specially appointed disinformation teams within the Civil Service and other media organisations) contracted by Cameron, left Scots feeling bruised and abused by a greedy, corrupt and self serving governmental system, within which Scotland has no future if it is to survive.
There is another way and that is INDEPENDENCE. Scot’s need not fear the future in an independent Scotland but there is no future in remaining with Westminster.
One example: Osborne reduced the top rate of tax from 50p to 45p. This made the rich even richer. But who paid for the reduction? Scottish pensioners met the cost through a reorganisation of pension entitlement reducing their benefits.
LikeLiked by 1 person